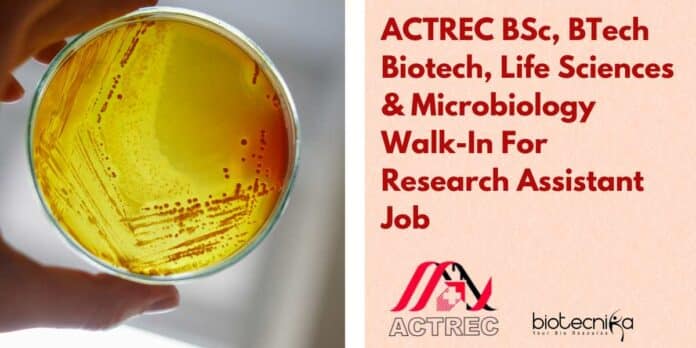

ACTREC BSc, BTech Biotech, Life Sciences & Microbiology Walk-In For Research Assistant Job
ACTREC BSc, BTech Biotech, Life Sciences & Microbiology Walk-In For Research Assistant Job. Research Assistant at ACTREC. BSc or B.Tech in Microbiology/Biotechnology/Life Sciences. candidates attend the walk-in interview at ACTREC. Interested candidates can check the details below and apply.
This job expires in
TATA MEMORIAL CENTRE
ADVANCED CENTRE FOR TREATMENT, RESEARCH AND
EDUCATION IN CANCER
Kharghar, Navi Mumbai- 410 210
www.actrec.gov.in
Phone No : 91-22-27405000/ Extn.:5353/5082
(A Grant-in-aid Institution of the Dept. of Atomic Energy, Government of India)
No. ACTREC/ADVT-88/2023 14.07.2023
WALK-IN-INTERVIEW FOR
RESEARCH ASSISTANT
(ON PROJECT)
Position: Research Assistant
No. of Posts: 01
DURATION: Six months. The work progress of candidate will be monitored and extension may be given 6 months.
How to Apply:
Eligible Candidates may attend the walk in interview on Thursday, 27th July 2023, in Meeting Room 2, 3rd Floor, Khanolkar Shodhika, ACTREC, Kharghar – 410210 along with recent CV & original and attested copies of all certificates and testimonials with recent passport size photograph and ID Proof. (preferably Aadhaar Card)
REPORTING TIME: 10:00 a.m. to 10:30 a.m.
ESSENTIAL QUALIFICATION:- BSc or B.Tech in Microbiology/Biotechnology/Life Sciences.
DESIRABLE: CMLT/DMLT/ADMLT from a recognized University/Board/MSBTE.
CONSOLIDATED SALARY: Rs. 21,000/-p.m.
Check the notification below
Here are a few interview questions with answers to do good at the walk in interview for the position of Research Assistant at ACTREC:
1.Can you tell us about your academic background and how it aligns with the requirements of this Research Assistant position? Answer: I hold a BSc degree in Microbiology, which provided me with a strong foundation in the fundamental principles of the field. Additionally, I have undertaken various projects during my undergraduate studies that involved conducting laboratory research and data analysis, which closely relates to the responsibilities of a Research Assistant. My educational background in Microbiology has equipped me with the necessary knowledge and skills to contribute effectively to this project.
2.How familiar are you with laboratory techniques and equipment commonly used in Microbiology and Biotechnology research? Answer: I am well-versed in a wide range of laboratory techniques commonly used in Microbiology and Biotechnology research. During my academic journey, I have gained hands-on experience in microbial culture techniques, DNA extraction, PCR, gel electrophoresis, and other essential procedures. Moreover, my enthusiasm for continuous learning drives me to stay updated with the latest advancements in the field, ensuring I am well-prepared to handle any tasks related to laboratory work.
3.The project requires a candidate who can work efficiently as part of a team. Can you provide an example of a successful teamwork experience from your past? Answer: Certainly! During my final year project, I collaborated with a team of four students to investigate the impact of different environmental factors on microbial growth. Each team member was assigned specific tasks, and my responsibility was to analyze the collected data and prepare graphical representations for the final presentation. By maintaining open communication, dividing the workload effectively, and supporting each other, we completed the project on time and achieved exceptional results. This experience taught me the importance of teamwork and how it contributes to the success of a research project.
4.How do you plan to ensure accuracy and precision in your work during the six-month duration of this project? Answer: To maintain accuracy and precision in my work, I believe in following a systematic approach. Firstly, I will carefully plan and organize each experiment to minimize the possibility of errors. Secondly, I will double-check all measurements and data entry to avoid any mistakes. Additionally, I will maintain a detailed lab notebook to record every step of the experimental process accurately. If I encounter any uncertainties, I will consult with my colleagues and supervisor to seek clarification. My commitment to maintaining the highest standard of accuracy will ensure reliable results and contribute to the success of the project.
5. The project may require flexibility and adaptability to handle unforeseen challenges. How do you handle unexpected setbacks or changes in a research environment? Answer: In a research environment, unexpected challenges are not uncommon. To handle such situations, I rely on my adaptability and problem-solving skills. When faced with a setback, I first analyze the root cause and try to understand the implications on the overall project. I am not afraid to seek guidance from my colleagues or supervisor to explore alternative approaches. Moreover, I maintain a positive outlook and use setbacks as opportunities for learning and growth. By staying open to new ideas and remaining flexible, I believe I can overcome any challenges that may arise during the project.
Editor’s Note: ACTREC BSc, BTech Biotech, Life Sciences & Microbiology Walk-In For Research Assistant Job. Please ensure you are subscribed to the Biotecnika Times Newsletter and our YouTube channel to be notified of the latest industry news. Follow us on social media like Twitter, Telegram, Facebook